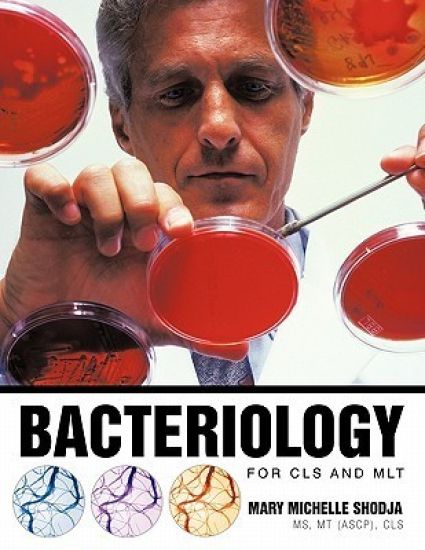
Bacteriology for CLS and MLT

Women, Change, and Iran
Michelle M T Letcher · ISBN 9781025129075
Julkaistu 2025 Kieli englanti sidottu
1000 tulosta hakusanalla Michelle M T Letcher.

Michelle M T Letcher · ISBN 9781025129075
Julkaistu 2025 Kieli englanti sidottu

Michelle M T Letcher · ISBN 9781025132273
Julkaistu 2025 Kieli englanti pokkari

Michelle M T Letcher · ISBN 9781288333196
Julkaistu 2012 Kieli englanti pokkari

Michelle M. Griffin · ISBN 9781419696954
Julkaistu 2008 Kieli englanti nidottu
"Elephants Can't Change but Leopards Can " combines a unique combination of humor, storytelling, and research with real world examples. Read about the antics of an Elephant Corp...

Michelle M Jacob · ISBN 9781734615142
Julkaistu 2021 Kieli englanti pokkari
Fox Doesn't Wear a Watch: Lessons from Mother Nature's Classroom celebrates the power and wisdom of lessons we can learn when we reevaluate our relationship to place and time. S...
"God Don't Make Junk" inspires children to celebrate their individuality, affirming that every person has their own special talent, even if it's not immediately obvious. With it...
"God Don't Make Junk" inspires children to celebrate their individuality, affirming that every person has their own special talent, even if it's not immediately obvious. With it...

Michelle M. Henning; Daniel T. Henning · ISBN 9781979523684
Julkaistu 2017 Kieli englanti nidottu
Wyatt Earp, Doc Holliday, Ed Schieffelin - these figures from history all walked down the same dusty streets of the same mining boom town. In this book, you or your student will...

James T. Monroe; Michelle M. Hamilton; David A. Wacks · ISBN 9780674251694
Julkaistu 2021 Kieli englanti nidottu
Spanish Arabism was a touchstone of the major intellectual and political issues facing Spain as it emerged from its imperial past into its current form as a modern nation-state....

H. Joachim Deeg; David T. Bowen; Steven D. Gore; Torsten Haferlach; Michelle M. Le Beau; Charlotte Niemeyer · ISBN 9783662517925
Julkaistu 2016 Kieli englanti nidottu
The diagnosis of myelodysplastic syndromes (MDS), a heterogeneous group of clonal hematopoietic disorders, is being made with increasing frequency over the past decade owing to...

T M Rives; Michelle Young · ISBN 9782361957261
Julkaistu 2024 Kieli englanti nidottu
Let Secret New York guide you around the unusual and unfamiliar. Step off the beaten track with this fascinating and unusual New York guide book and let our local experts show y...

Michelle Honey Thomas · ISBN 9781735597409
Julkaistu 2020 Kieli englanti nidottu
This book is about boosting children's self-esteem. It helps them believe in themselves and know they can do anything if they put their minds to it and work hard. Shad and JuJu...

Michelle's Notebook · ISBN 9781729466360
Julkaistu 2018 Kieli englanti nidottu
Funny Notebook Is A Perfect and Ideal Gift For Boys And Girls Who Love Unicorns. Are You Unicorn Lovers? Then You Do Not Want To Miss Having This Lovely Unicorn Notebook To Writ...

Michelle's Notebook · ISBN 9781729466384
Julkaistu 2018 Kieli englanti nidottu
Funny Notebook Is A Perfect and Ideal Gift For Boys And Girls Who Love Unicorns. Are You Unicorn Lovers? Then You Do Not Want To Miss Having This Lovely Unicorn Notebook To Writ...

Jeremy M Eckhause; David T Orletsky; Aaron C Davenport; Mel Eisman; Raza Khan; Jonathan Theel; Marc Thibault; Dulani Woods; Michelle D Ziegler · ISBN 9781977403858
Julkaistu 2020 Kieli englanti nidottu
Because U.S. Coast Guard (USCG) rotary-wing aircraft are nearing their ends of life, the USCG is reassessing its airpower needs for its current missions and future operational r...

Jeffrey Martini; Sean M Zeigler; Sebastian Joon Bae; Alexandra T Evans; Gian Gentile; Michelle Grisé; Mark Hvizda · ISBN 9781977407689
Julkaistu 2022 Kieli englanti pokkari

Michele M Gold · ISBN 9789657589106
Julkaistu 2014 Kieli englanti nidottu
Mary Michelle Shodja MS MT (ASCP) CLS · ISBN 9781426940521
Julkaistu 2010 Kieli englanti pokkari

Mary Michelle Shodja MS MT (ASCP) CLS · ISBN 9781426943997
Julkaistu 2011 Kieli englanti pokkari